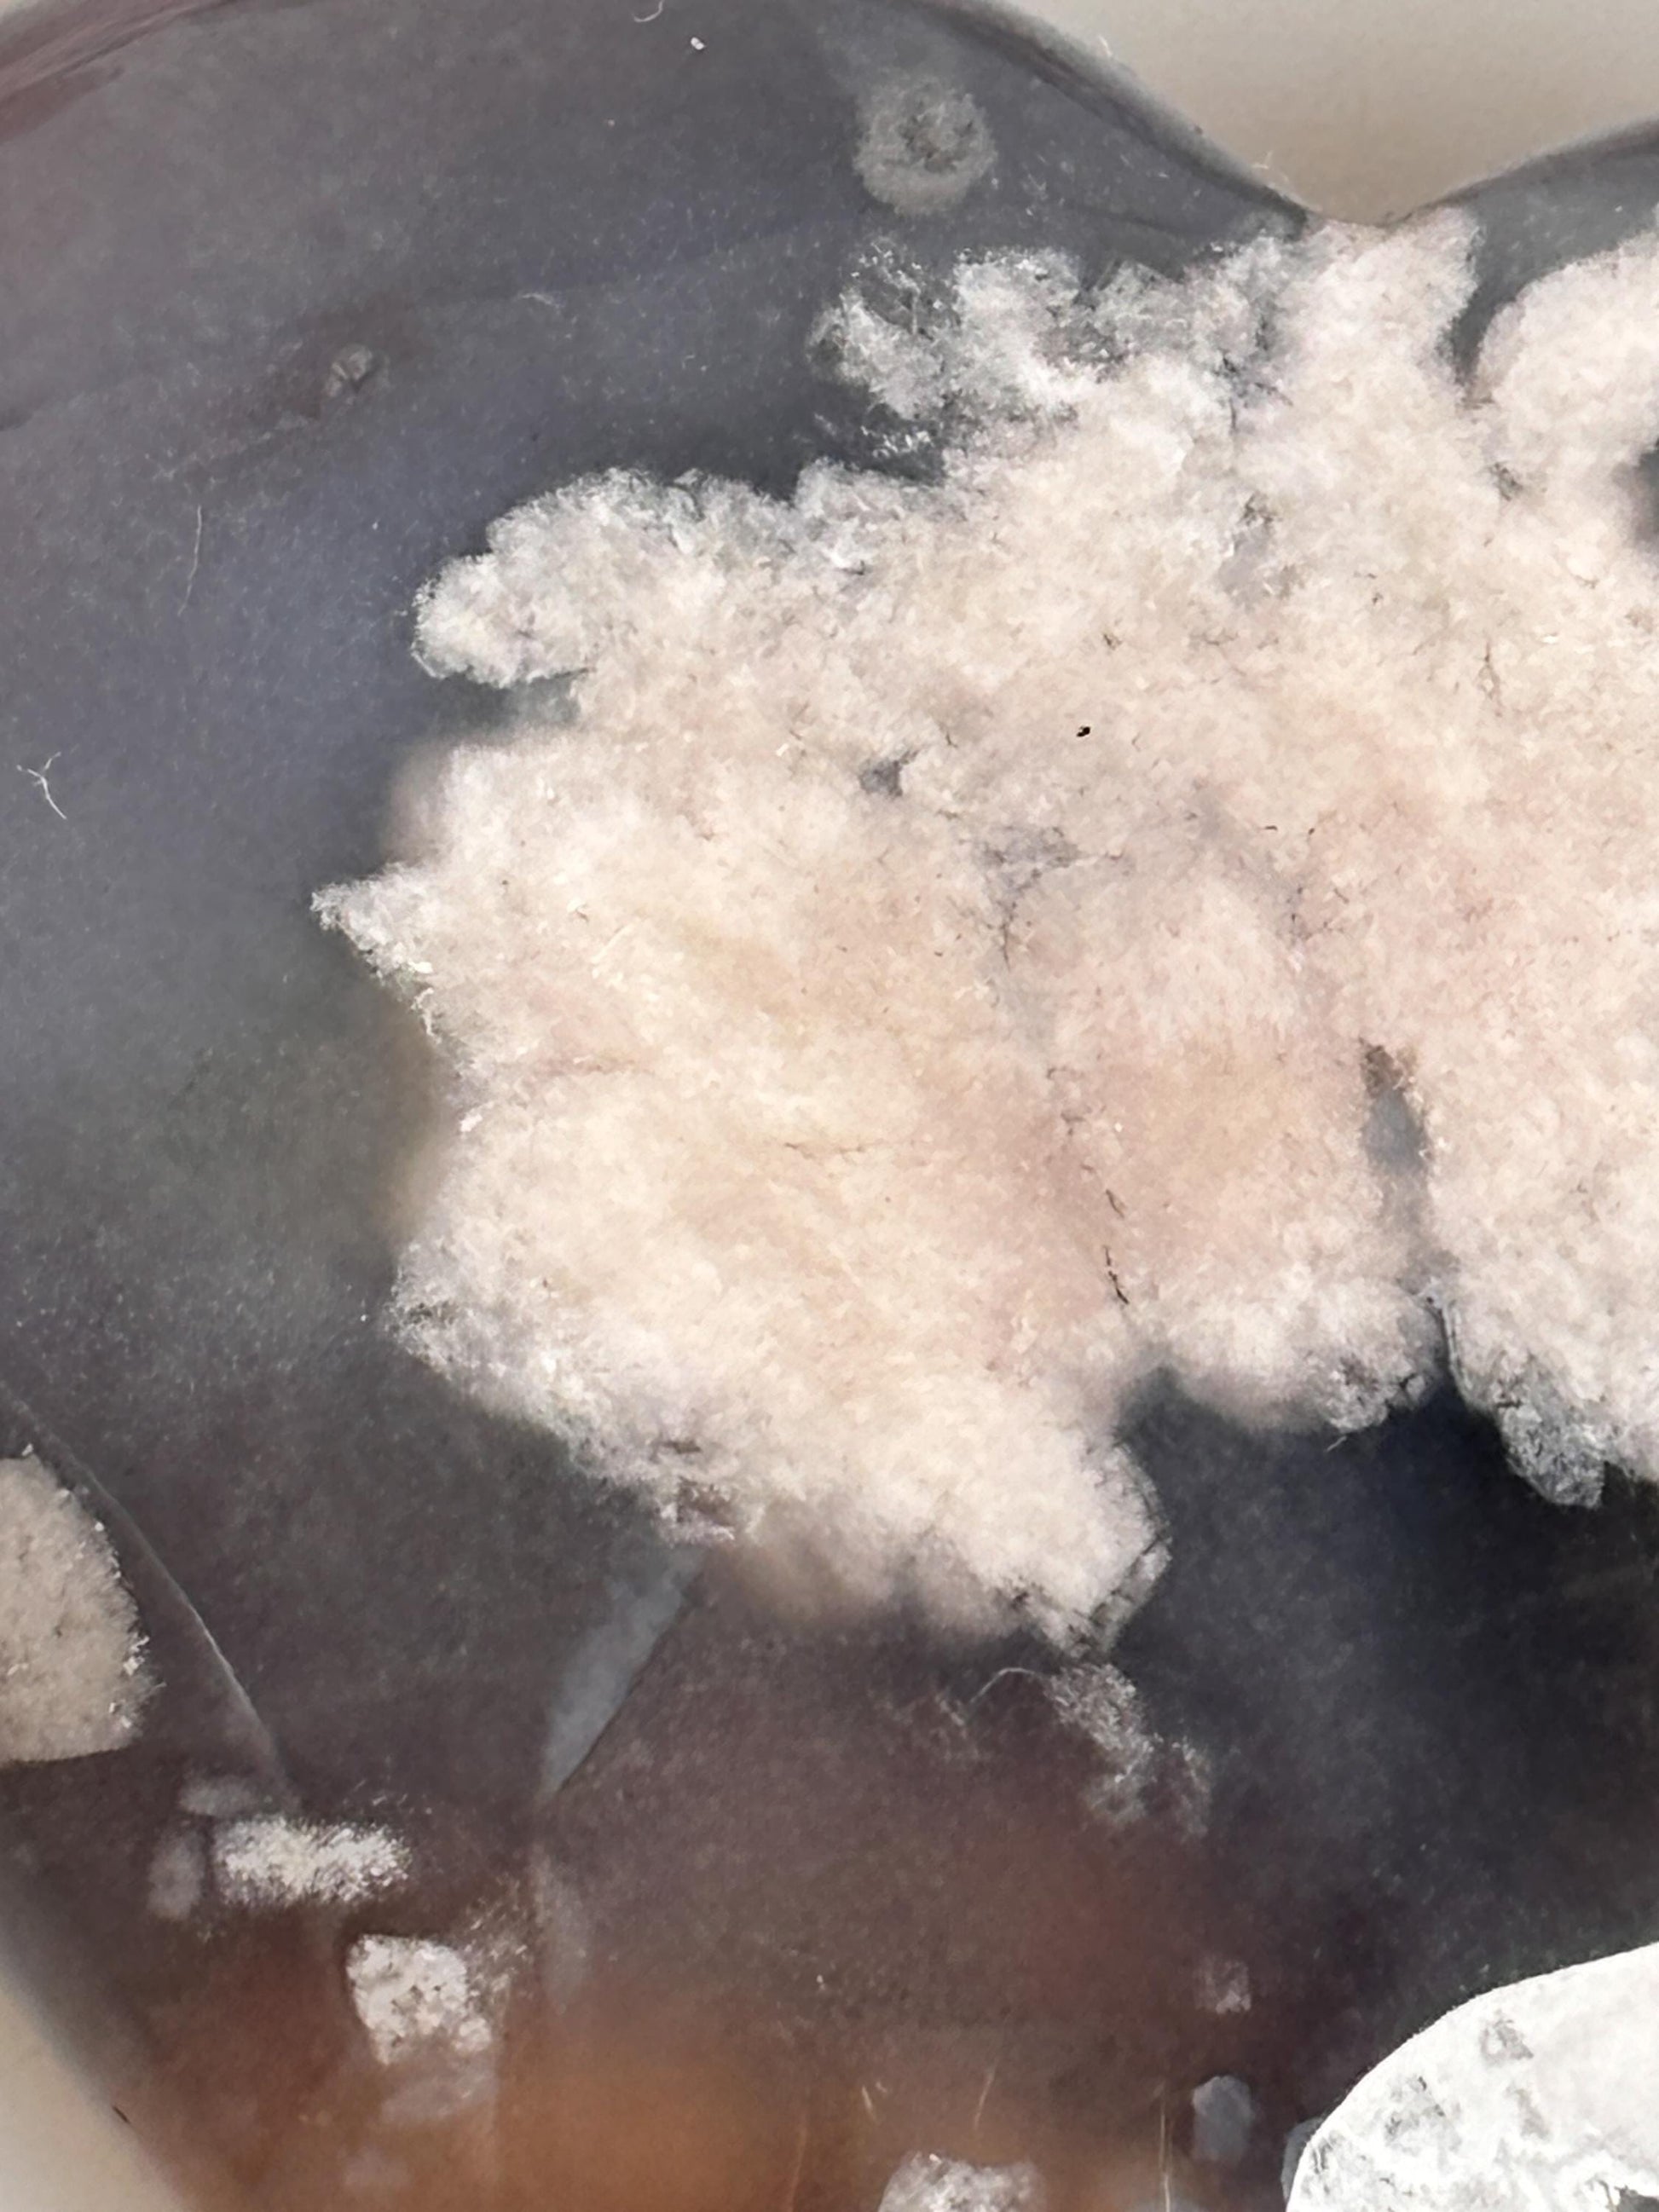

Etsy
Blaues Blumenachat Herz | Heilstein Kristall für Achtsamkeit & Energiearbeit | Geschenkidee für Kristallliebhaber
Blaues Blumenachat Herz | Heilstein Kristall für Achtsamkeit & Energiearbeit | Geschenkidee für Kristallliebhaber
Regular price
€32,00 EUR
Regular price
Sale price
€32,00 EUR
Unit price
per
Shipping calculated at checkout.
Couldn't load pickup availability
Dieses bezaubernde blaue Blumenachat Herz (ca. 5,1 x 4,6 x 1,6 cm, 47g) ist ein einzigartiger Begleiter für deine spirituelle Reise und ein wunderschönes Dekoelement. Blumenachat, auch als “Stein der Selbstakzeptanz bekannt, fördert laut Überlieferung das emotionale Gleichgewicht und stärkt das Selbstvertrauen. Die sanften, blauen Muster verleihen Ruhe und Harmonie perfekt, um negative Energien auszugleichen und innere Stärke zu fördern.
Symbolik und Wirkung: Blumenachat wird oft zur Beruhigung von Geist und Seele verwendet und unterstützt dich dabei, dich auf deine Stärken zu konzentrieren. Der Stein eignet sich ideal für Meditation, Energiearbeit oder als täglicher Begleiter in deinem Zuhause oder Büro. Blaues Blumenachat ist bekannt dafür, das Selbstvertrauen zu fördern und negative Gedanken zu mildern.
Einzigartiges Geschenk: Dieses Herz aus Blumenachat ist ein besonderes Geschenk für Kristallliebhaber, die Ruhe und positive Energie suchen. Ein symbolischer und schöner Stein, der als Liebesgeschenk oder für die Selbstfürsorge eine perfekte Wahl ist.
Haftungsausschluss: Dieser Artikel dient nur dekorativen und spirituellen Zwecken und ersetzt keine medizinische oder therapeutische Behandlung. Es wird kein Heilversprechen gegeben.
Symbolik und Wirkung: Blumenachat wird oft zur Beruhigung von Geist und Seele verwendet und unterstützt dich dabei, dich auf deine Stärken zu konzentrieren. Der Stein eignet sich ideal für Meditation, Energiearbeit oder als täglicher Begleiter in deinem Zuhause oder Büro. Blaues Blumenachat ist bekannt dafür, das Selbstvertrauen zu fördern und negative Gedanken zu mildern.
Einzigartiges Geschenk: Dieses Herz aus Blumenachat ist ein besonderes Geschenk für Kristallliebhaber, die Ruhe und positive Energie suchen. Ein symbolischer und schöner Stein, der als Liebesgeschenk oder für die Selbstfürsorge eine perfekte Wahl ist.
Haftungsausschluss: Dieser Artikel dient nur dekorativen und spirituellen Zwecken und ersetzt keine medizinische oder therapeutische Behandlung. Es wird kein Heilversprechen gegeben.
View full details